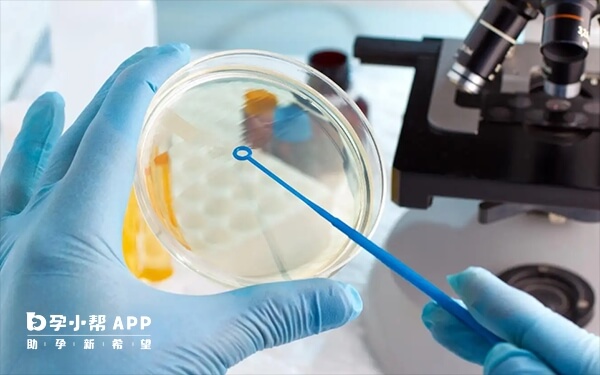
试管婴儿建议移植单胎

孕前高血压是不良妊娠事件的危险因素,如先兆子痫,胎儿生长受限,胎盘早剥和新生儿不良事件。所以,做试管婴儿时,血压140和90是不建议移植2枚胚胎的。考虑到妊娠的案例问题,对于高血压患者,通常医生会建议移植一个胚胎。记住:怀孕不是目的,生一个健康的宝宝才是。

根据世界卫生组织(WHO)及中国高血压防治指南,高血压分为以下级别:
1级高血压:收缩压140-159mmHg和/或舒张压90-99mmHg;
2级高血压:收缩压160-179mmHg和/或舒张压100-109mmHg;
3级高血压:收缩压≥180mmHg和/或舒张压≥110mmHg;
单纯收缩期高血压:收缩压≥140mmHg且舒张压<90mmHg(常见于老年人)。
由上可见,血压140和90已属于一级高血压,这种情况下,医生是不建议做双胎移植的。
临床数据显示,多移植一个胚胎,怀孕率只增加大约5%。虽然多胞胎率提高了,但早产几率相比单胚胎移植增加了27%左右。所以,如果胚胎质量不错,子宫内膜没有问题,移植一枚胚胎怀孕的概率就已经很高,没必要移植两枚。
另外,在辅助生殖领域也有严格的规定,母体存在以下情况时,不管是D3卵裂期胚胎还是D5或D6的囊胚,均建议移植一个胚胎。
1、子宫因素不适宜于双胎妊娠者:
①既往因剖宫产、子宫肌瘤剥除等导致的疤痕子宫者;
②患有单角子宫、双子宫等子宫畸形或经过手术矫形治疗者;
③患有子宫颈机能不全者;
④既往曾有流产早产史等不良孕产史者。
2、全身状况不适宜双胎妊娠者:
①全身性的疾病得到有效控制者:如糖耐病、高血压患者;
②身高<150cm、体重<40Kg者。
3、经三代试管婴儿助孕者,只能移植一个胚胎;
4、接受G卵助孕者也只能移植一个胚胎。
文章更新时间:2025-09-2013:49:39
位姐妹
高龄/绝经试管
助孕攻略群
位姐妹
不孕不育
助孕经验群
位姐妹
染色体异常
备孕交流群
位姐妹
三代/四代试管
助孕交流群